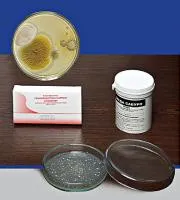

Nutrient chemical mediain Samara region
check the price
preorder
Лаурил сульфат триптозный бульон
АллХим
(Russia) Belgorod
Бульон лаурил -сульфатный – это селективная среда, которая используется для подсчета колиформ в воде и молочных продуктах, а также для тестов, подтверждающих ферментацию лактозы колиформами с образованием газа. Сух...

check the price
preorder
Пептонная безиндольная вода
АллХим
(Russia) Belgorod
Сухая питательная среда для идентификации бактерий Escherichia coli. ГОСТ Р 52830-2007 Фасовка в пластиковые банки по 100 г. Расход среды 15 г/дм3. Страна Россия Производитель: ООО "НПЦ "Биокомпас-С" Углич

check the price
preorder
Среда Донована
АллХим
(Russia) Belgorod
Предназначена для обнаружения Bacillus cereus при санитарно-гигиенических исследованиях продуктов питания, сырья и контроле их производства. Содержит селективный агент хлорид лития. ГОСТ 10444.8-88 Фасовка в пластиковые ...

check the price
preorder
Солевой агар с 2,3,5-ТТХ
АллХим
(Russia) Belgorod
Сухая питательная среда с полимиксином и 2,3,5-трифенилтетразолия хлоридом предназначена для обнаружения Bacillus cereus при санитарно-гигиенических исследованиях продуктов питания, сырья и контроле их производства. ГОСТ...

check the price
preorder
Среда типа М 17 для определения термофильных стрептококков
АллХим
(Russia) Belgorod
Среда типа М 17 используется для определения термофильных стрептококков в молочной промышленности. Фасовка в пластиковые банки по 100 г. Расход среды 55 г/дм3. Страна Россия Производитель: ООО "НПЦ "Биокомпас-С" Углич

check the price
preorder
Бульон солевой
АллХим
(Russia) Belgorod
Предназначен для приготовления жидких и плотных питательных сред, используемых при проведении микробиологических исследований. Среда элективная солевая - питательная среда для выделения стафилококков, сухая представляет ...

check the price
preorder
Среда типа MRS (агаризованная) для определения лактобактерий
АллХим
(Russia) Belgorod
Среда применяется при контроле пищевых продуктов для выявления или подсчёта НВЧ молочнокислых микроорганизмов. Сухая питательная среда выпускается в комплекте с твином-80. Расход сухой питательной среды -60 г/л. Страна Р...

check the price
preorder
Среда типа MRS (жидкая) для определения лактобактерий
АллХим
(Russia) Belgorod
Среда типа MRS (жидкая) для лактобактерий . Среда применяется при контроле пищевых продуктов для выявления или подсчёта НВЧ молочнокислых микроорганизмов. Сухая питательная среда выпускается в комплекте с твином-80. Расх...

check the price
preorder
Селективная среда с маннитом и желчью
АллХим
(Russia) Belgorod
Применяется для приготовления жидкой селективной среды. В качестве селективных агентов, наряду с маннитом и бычьей желчью, в этой среде используются полимиксин, а также индикаторная система кристаллвиолет - бромтимоловый...

check the price
preorder
Агар с цитратом натрия
АллХим
(Russia) Belgorod
Среда используется для определения способности бактерий рода Providencia утилизировать цитраты. Бактерии рода Morganella цитраты не утилизируют. Фасовка в пластиковые банки по 100 г. Расход среды 25 г/дм3. Страна Россия ...

check the price
preorder
Декстрозный селективный агар (агар Сабуро с хлорамфениколом)
АллХим
(Russia) Belgorod
Используется для выявления дрожжей и плесневых грибов. Фасовка в пластиковые банки по 100 г. Расход среды 65 г/дм3. Страна Россия Производитель: ООО "НПЦ "Биокомпас-С" Углич
check the price
preorder
Агар лактозный с бриллиантовым зеленым и феноловым красным
АллХим
(Russia) Belgorod
Применяется для определения и учета колиформных бактерий. ГОСТ Р 52816-2007 Фасовка в пластиковые банки по 100 г. Расход среды 50 г/дм3. Страна Россия Производитель: ООО "НПЦ "Биокомпас-С" Углич

check the price
preorder
Среда железосульфитная вязкая (0,15% агар) - ЖСС-1
АллХим
(Russia) Belgorod
Железосульфитная среда ЖСС-1 применяется для определения сульфитредуцирующих клостридий в различных видах продовольственного сырья и пищевых продуктов. ГОСТ 29185-91 Аналогична по составу среде Вильсон-Блера. Используетс...

check the price
preorder
Среда железосульфитная плотная (1,5% агара) - ЖСС-2
АллХим
(Russia) Belgorod
ЖСС - 2 - железосульфитная среда , содержащая 1 , 5 % агара ; используется для приготовления плотной агаризованной среды . Железосульфитная среда плотная предназначена для выявления и определения количества сульфитредуци...

check the price
preorder
Среда лактатно-ацетатная для селективного учета споровых анаэробов (среда ЛАССА)
АллХим
(Russia) Belgorod
Среда Ласса (лактатно-ацетатная для учета мезофильных лактатсбраживающих анаэробных бактерий). Питательная среда — вещество или смесь веществ, применяемая для культивирования макро- и микроорганизмов. Существует мн...

check the price
preorder
Пит. среда №1 ГРМ Набор реагентов для количественного опр. микробной загрязненности без НДС
АллХим
(Russia) Belgorod
Описание Питательная среда № 1 ГРМ-агар сухая, предназначена для приготовления агаровых сред для культивирования и подсчета общего числа аэробных бактерий при контроле микробной загрязненности нестерильных лекарственных ...

check the price
preorder
АГАР Мюллера-Хинтон II (цена за 1 кг) без НДС
АллХим
(Russia) Belgorod
Питательная среда для определения чувствительности микроорганизмов к антибактериальным препаратам, сухая. Страна Россия Производитель: ФБУН"Государственный научный центр микробиологии и биотехнологии"

check the price
preorder
Бульон МакКонки-ГРМ (цена за 1 кг) без НДС
АллХим
(Russia) Belgorod
Питательная среда для обнаружения E.coli и колиформных бактерий, сухая. Страна Россия Производитель: ФБУН"Государственный научный центр микробиологии и биотехнологии"

check the price
preorder
Питательная среда №14 ГРМ (цена за 1 кг) без НДС
АллХим
(Russia) Belgorod
Набор реагентов для контроля микробной загрязненности (цитратный агар Симмонса). Страна Россия Производитель: ФБУН"Государственный научный центр микробиологии и биотехнологии"

check the price
preorder
Питательная среда №2 ГРМ (Сабуро) (цена за 1 кг) без НДС
АллХим
(Russia) Belgorod
Набор реагентов для контроля микробной загрязненности (для выращивания грибов). Страна Россия Производитель: ФБУН"Государственный научный центр микробиологии и биотехнологии"

check the price
preorder
Среда Кэри-Блэра (цена за 1 кг) без НДС
АллХим
(Russia) Belgorod
Транспортная среда Кэри-Блэра, сухая. Страна Россия Производитель: ФБУН"Государственный научный центр микробиологии и биотехнологии"

check the price
preorder
Среда Эймса (с углем) (цена за 1 кг) без НДС
АллХим
(Russia) Belgorod
Транспортная среда Эймса, сухая (мод. с углем). Страна Россия Производитель: ФБУН"Государственный научный центр микробиологии и биотехнологии"

check the price
preorder
Среда Эймса (без угля) (цена за 1 кг) без НДС
АллХим
(Russia) Belgorod
Транспортная среда Эймса, сухая (мод. без угля). Страна Россия Производитель: ФБУН"Государственный научный центр микробиологии и биотехнологии"

check the price
preorder
Среда Левенштейна Йенсена (5 пробирок) без НДС
АллХим
(Russia) Belgorod
Питательная среда для выделения и культивирования микобактерий, готовая к применению. 5 пробирок в упаковке. Страна Россия Производитель: ФБУН"Государственный научный центр микробиологии и биотехнологии"

check the price
preorder
Сульфитный агар мод.1 (цена за 1 кг) без НДС
АллХим
(Russia) Belgorod
Питательная среда для выявления клостридий по сульфитредуцирующему признаку сухая (агар 1,5 г/л) Страна Россия Производитель: ФБУН "Государственный научный центр микробиологии и биотехнологии"

check the price
preorder
Сульфитный агар мод.2 (цена за 1 кг) без НДС
АллХим
(Russia) Belgorod
Питательная среда для выявления клостридий по сульфитредуцирующему признаку сухая (агар 7,0+-1 г/л). Страна Россия Производитель: ФБУН"Государственный научный центр микробиологии и биотехнологии"

check the price
preorder
Сульфитный агар мод.3 (цена за 1 кг) без НДС
АллХим
(Russia) Belgorod
Питательная среда для выявления клостридий по сульфитредуцирующему признаку сухая (агар 17,5+-2,5 г/л). Страна Россия Производитель: ФБУН"Государственный научный центр микробиологии и биотехнологии"

check the price
preorder
Тест-полоска Listeria spp.
АллХим
(Russia) Belgorod
Набор реагентов для быстрой идентификации листерий. 10 полосок в пластиковой пробирке (по заявке). Страна Россия Производитель: ФБУН"Государственный научный центр микробиологии и биотехнологии"

check the price
preorder
Тест-полоска L.pneumophila 1
АллХим
(Russia) Belgorod
Набор реагентов для быстрой идентификации возбудителя легионеллеза. 10 полосок в пластиковой пробирке (по заявке). Страна Россия Производитель: ФБУН"Государственный научный центр микробиологии и биотехнологии"

check the price
preorder
КМАФАнМ (цена за 1 кг) без НДС
АллХим
(Russia) Belgorod
Питательная среда для определения количества мезофильных аэробных и факультативно-анаэробных микроорганизмов, сухая. Страна Россия Производитель: ФБУН"Государственный научный центр микробиологии и биотехнологии"
|
|
2009-2025 © All Rights Reserved
|